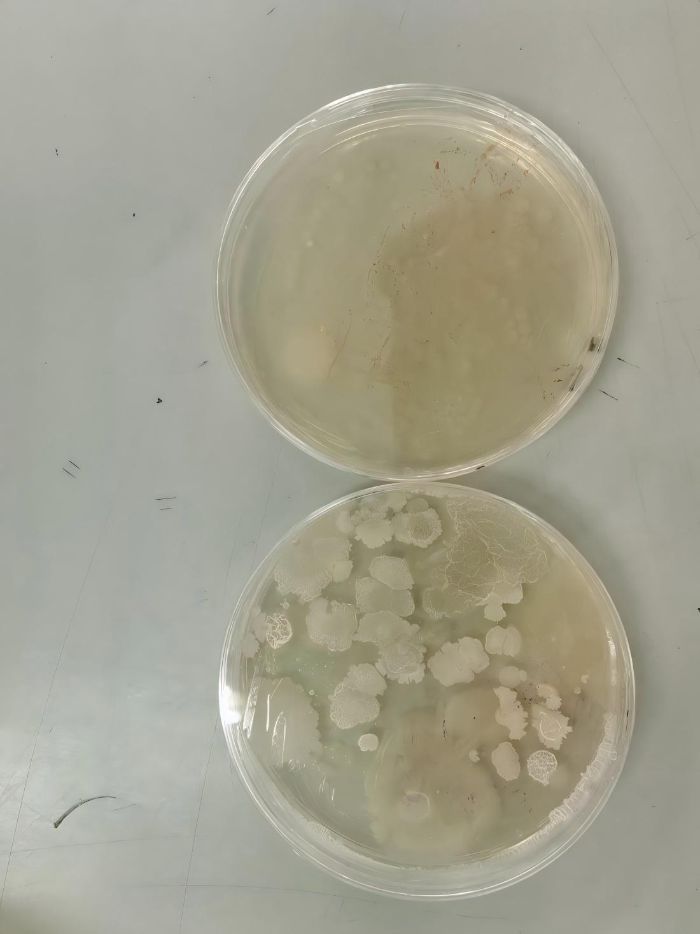

“逐夢東林”小水滴公益課堂是東北林業大學生命科學學院打造的特色公益項目,也是充滿特色的社會實踐活動,項目于2016年寒假開始舉辦,現已成功舉辦多期。讓小朋友們在講師團的帶領下進行各種各樣的小實驗,學習其中的科學知識,讓小朋友們在活動中體驗,在情境中感受,在過程中成長。值得一提的是,本次課程還邀請了生物方向研究生強勢加盟講師團,分子生物學主題課程“神奇的生命密碼DNA”與東北林業大學國際基因工程大賽(iGEM)團隊NEFU-China合作。從2025年初的想法萌芽,到暑假實踐的圓滿落幕,半年時光里,我們緊鑼密鼓的完成了講師團人員選拔、設計和完善課程主題、制作課堂課件等工作,完成了3次線上試講、3次線上會議、2次線下試講,最終組成了匯聚生命科學學院生物專業和食品專業的本研共19名學生的實踐團隊。
圖為開班儀式上,帶隊老師欒曉欣在為小朋友們介紹四天的課程安排。仲依娜攝

圖為《隱形的神秘世界》課堂上,主講老師在為小朋友們展示洗手前與洗手后的菌群數量對比,督促小朋友們養成勤洗手的好習慣。程好攝
圖為《隱形的神秘世界》課堂上的洗手前與洗手后的菌群數目對比,左為洗手前的菌群。韓易彤攝

圖為《光的神奇之旅》課程中,了解過光沿直線傳播的知識后,助教老師們為小朋友們帶來手影表演。郎曈彤攝

圖為《光的神奇之旅》課堂中,小朋友們進行光的反射實驗。仲依娜攝

圖為《奇妙的聲音世界》課堂上,助教老師帶領小朋友親身體會聲音可以在水中傳播。李顯昊攝

圖為《奇妙的聲音世界》課堂上,小朋友們在用剛剛制作好的紙杯電話與同伴通話。程好攝

圖為《指紋的秘密》課堂上,小朋友展示自己用指紋繪畫出來的彩色小樹。程好攝

圖為《神奇的生命密碼DNA》課堂上,助教老師為大家示范提取香蕉的DNA的實驗步驟。武曉艷攝

圖為《神奇的生命密碼DNA》課堂上,主講老師幫助小朋友提取香蕉的DNA。程好攝

圖為《看不見的魔法》課堂上,小朋友利用正負電荷相互吸引的知識釣“小魚”。仲依娜攝

圖為結業儀式上,小朋友與媽媽一起進行默契大比,拼培養親子感情。武曉艷攝

圖為植物網志愿者楊艷琦同學為小朋友們介紹林場中的植物。李顯昊攝

圖為結業儀式上為小朋友們頒發“全勤標兵”獎狀并贈送小禮品。程好攝

圖為課程的最后,小朋友與老師們在林場中的大合照。李顯昊攝